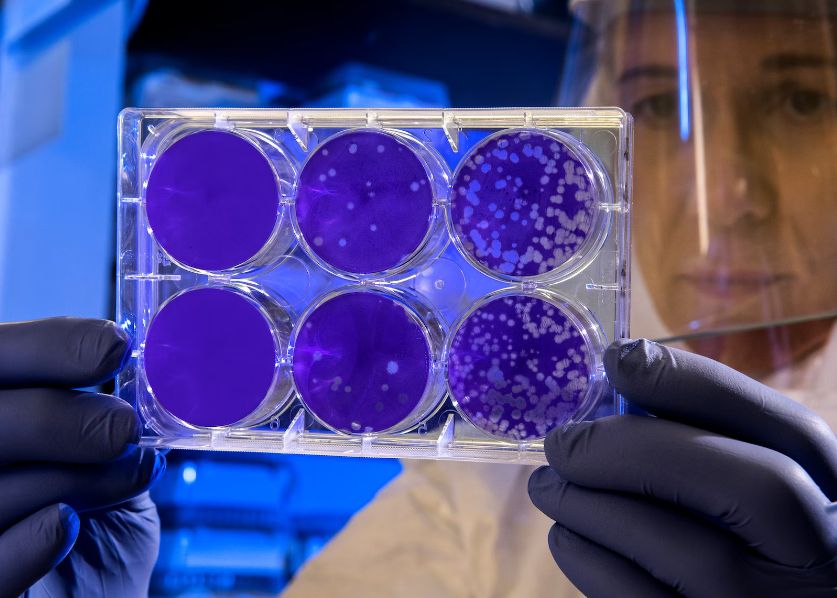
Model Matematic Intrigant Gasit In Celulele Corpului Uman

Model matematic intrigant găsit în celulele corpului uman
De la corpusculii purtători de oxigen din sângele nostru până la neuronii ramificați care ne guvernează gândurile, corpul nostru este alcătuit dintr-o varietate extraordinară de celule.
Cercetători de la instituții din Germania, Canada, Spania și SUA au publicat un studiu cuprinzător despre celulele individuale de fiecare tip care există în corpurile tipice.
Pe baza unei analize exhaustive a peste 1.500 de surse publicate, aceștia au ajuns la concluzia că majoritatea bărbaților adulți au în corp un total de aproximativ 36 de trilioane de celule, în timp ce femeile adulte tind să aibă aproximativ 28 de trilioane de celule. Un copil de 10 ani, prin comparație, ar avea în jur de 17 trilioane.
Pe lângă numărul total de celule, studiul a dezvăluit ceva foarte interesant: dacă grupăm celulele în categorii în funcție de mărimea lor, fiecare categorie de mărime contribuie aproximativ în aceeași măsură la masa corpului.
„Aceste tipare sugerează un compromis la nivelul întregului organism între dimensiunea și numărul de celule și implică existența homeostaziei dimensiunii celulelor", scriu cercetătorii în lucrarea publicată.
Altfel spus, se pare că există un act de echilibrare naturală, în care se produc mai puține celule mari și mai multe celule mici pentru a menține categoriile echilibrate. Mai mult, variația de mărime în fiecare categorie a fost, de asemenea,relativ similară.
Având în vedere că dimensiunea relativă a celor mai mici celule din organism (cum ar fi celulele roșii din sânge, de exemplu) și a celor mai mari celule (cum ar fi fibrele musculare) este ca și cum am compara dimensiunea unui șoarece de munte cu cea a unei balene albastre, aceasta este o descoperire fascinantă.
După cum subliniază cercetătorii, celulele noastre sunt dimensionate perfect pentru diferitele lor roluri - și orice perturbare a acestei scale indică adesea prezența unei boli. Este în mod clar important ca acest tip de reglare celulară să aibă loc, iar acest lucru se face foarte inteligent.
Oamenii de știință au mai încercat anterior să estimeze numărul de celule din corpul nostru, iar noua cifră este apropiată de cele avansate în trecut, dar ceea ce face ca acest ultim studiu să fie special este modul în care încearcă să cerceteze și dimensiunile comparative ale celulelor.
Prin studiile viitoare oamenii de știință vor avea ocazia să analizeze modul exact în care corpul nostru reglează dimensiunea și numărul de celule care ne fac să fim ceea ce suntem - și cum acționează această reglementare pentru a ne menține corpul sănătos și pentru a se asigura că el crește în mod normal.
Cercetătorii speră că descoperirile lor vor fi utile în multe studii diferite din domeniul biologiei - și cu acest scop în minte.
___________________________________________________________________________________________________